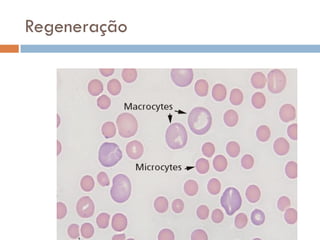
Regeneração
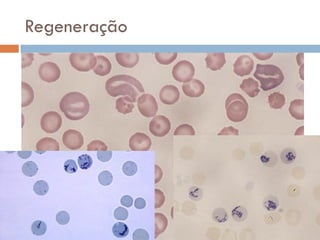
Regeneração
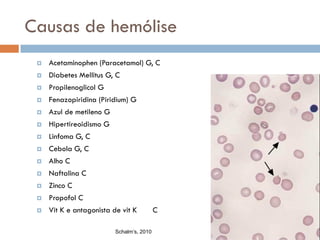
Causas de hemólise
    Acetaminophen (Paracetamol) G, C
    Diabetes Mellitus G, C
    Propilenoglicol G
    Fenazopiridina (Piridium) G
    Azul de metileno G
    Hipertireoidismo G
    Linfoma G, C
    Cebola G, C
    Alho C
    Naftalina C
    Zinco C
    Propofol C
    Vit K e antagonista de vit K          C

                          Schalm’s, 2010
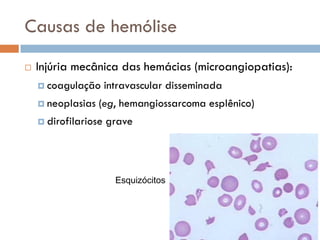
Causas de hemólise
   Injúria mecânica das hemácias (microangiopatias):
     coagulação      intravascular disseminada
     neoplasias   (eg, hemangiossarcoma esplênico)
     dirofilariose   grave




                        Esquizócitos
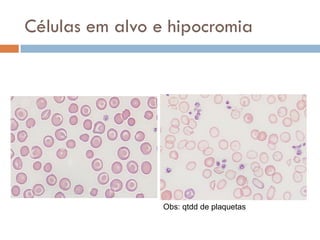
Células em alvo e hipocromia




                 Obs: qtdd de plaquetas
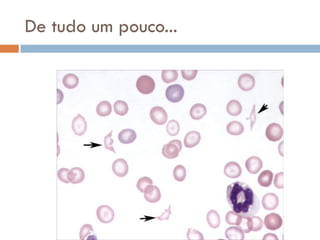
De tudo um pouco...
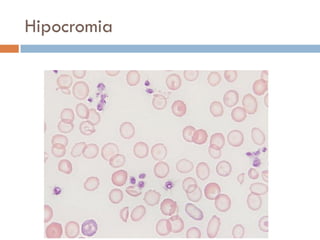
Hipocromia

O documento descreve a interpretação do eritrograma. Em três frases:
O texto explica a produção dos eritrócitos na medula óssea, sua vida útil no sangue periférico e os mecanismos de regulação da eritropoiese. Também aborda as causas de anemia, classificadas em regenerativas ou não regenerativas, e exemplos de alterações morfológicas encontradas em cada tipo.













![Hemoglobina
Regulação da afinidade da Hb pelo O2
natureza da Hb
pH
temperatura
2,3 DPG
• HbF, afinidd Hb/O2
• qto >[CO2], < pH afinidade da Hb
pelo O2 oxigenação tecidual
• temp, afinidd Hb/O2
• 2,3 DPG, afinidd Hb/O2](https://image.slidesharecdn.com/eritrograma-anclivepa2011-110514154613-phpapp02/85/Eritrograma-Anclivepa-2011-14-320.jpg)